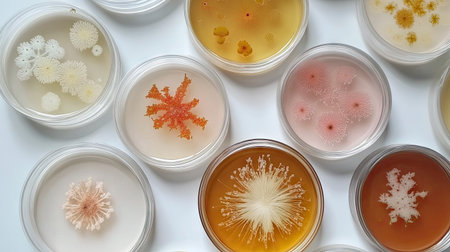
Petri dish with diverse bacterial cultures growing in vibrant colors, placed on a clean, white background, representing scientific research.の素材

素材 - Petri dish with diverse bacterial cultures growing in vibrant colors, placed on a clean, white background, representing scientific research.
作品情報
Petri dish with diverse bacterial cultures growing in vibrant colors, placed on a clean, white background, representing scientific research.
- ID:258942315
- 作品種別:
- 作者名:suphauarrn Manosri
キーワード
- adult
- antibiotic
- bacterial
- bacterium
- biochemistry
- biological
- biology
- biotechnology
- cell
- colony
- color image
- confidence
- coworker
- culture
- cultures
- disease
- equipment
- experiment
- females
- fungus
- growth
- health care
- healthcare and medicine
- holding
- horizontal
- hygiene
- indoors
- infection
- laboratory
- liquid
- macro
- medicine
- microbiology
- microscope
- mobile phone
- organism
- people
- pipette
- plate
- research
- science
- scientific
- spain
- species
- technology
- test
- two people
- yeast
類似作品
close-up of sci...
Close up view r...
Close up of bac...
petri dish fill...
Colorful variet...
Close-up of a s...
Laboratory petr...
Bacteria and vi...
petri dish with...
detail of bacte...
Macro close up ...
Mixed of bacter...
microbial cultu...
A cluster of va...
A top-down view...
Different bacte...
petri dish with...
Close-up of pet...
microbial cultu...
Backgrounds of ...
Macro close up ...
petri dish with...
microbial cultu...
close-up of vib...
bacteria colony...
A vibrant and c...
Close-up of pet...
microbial cultu...
Petri dish with...
Laboratory for ...
Petri dish with...
Colourful petri...
Bacteria in a p...
Scientist using...
microbial cultu...
petri dishes wi...
Magnifying glas...
microbial cultu...
Backgrounds of ...
Bacteria in a p...
Close up of pet...
Bacteria growin...
collection of d...
microbial cultu...
a close up imag...
Colonies of dif...
This striking i...
Macro close up ...
Detailed view o...